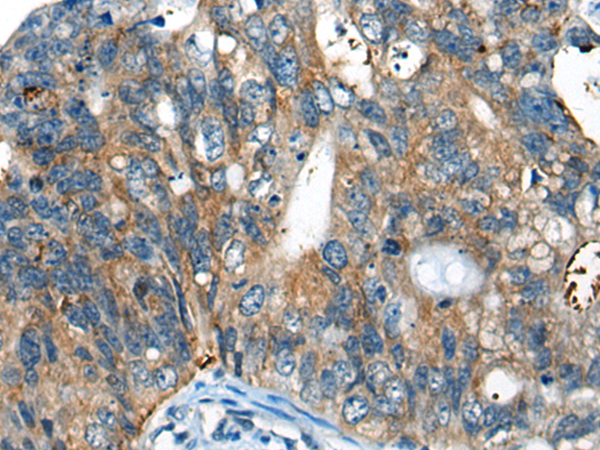

Background:
Members of the small leucine-rich proteoglycan (SLRP) family are mostly extracellular proteins that function upstream of multiple signaling cascades. They affect intracellular phosphorylation and modulate distinct pathways, such as those driven by Toll-like receptors, TGF∫ and receptor tyrosine kinases. As a member of the SLRP family, CHADL (Chondroadherin-like protein) is a 762 amino acid protein containing 21 LRR (leucine-rich) repeats, which promote protein-ligand interactions. Chondroadherin, a closely related protein, promotes attachment of chrondocytes, osteoblasts and fibroblasts and also plays an important role in the regulation of chrodrocyte proliferation and growth. CHADL is a secreted protein that is located in the extracellular space. There are two isoforms of CHADL that exist as a result of alternative splicing events. Potential negative modulator of chondrocyte differentiation. Inhibits collagen fibrillogenesis in vitro. May influence chondrocyte's differentiation by acting on its cellular collagenous microenvironment.
Applications:
ELISA, IHC
Name of antibody:
CHADL
Immunogen:
Synthetic peptide of human CHADL
Full name:
chondroadherin like
Synonyms:
SLRR4B
SwissProt:
Q6NUI6
ELISA Recommended dilution:
5000-10000
IHC positive control:
Human colorectal cancer
IHC Recommend dilution:
20-100
購物車
幫助
021-54845833/15800441009
